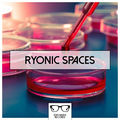

Top tracks
Playlists
Similar artists
Featured in
| Psyspheres |
| Goa Wisdom, Vol. 13 |
| Goa Trip, Vol. 10 |
| Psytrance Classics, Vol. 1 |
| Goa Trip, Vol. 4 |
| Goa Performers, Vol. 13 |
| Ryonic Spaces |
| Goa Summer 2010 |
| Ryonic Spaces: Compilaed by DJ Chemicus (Compiled by Chemicus) |
| Goa Trip, Vol. 4 |